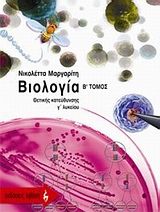

Βιβλία
-

Βιολογία Α΄ γενικού λυκείου
Συλλογικό έργο, Αντώνης Καστορίνης, Μαρία Κωστάκη - Αποστολοπούλου, Φωτεινή Μπαρώνα - Μάμαλη, Βασιλική Περάκη, Περικλής Πιαλόγλου
[Οργανισμός Εκδόσεως Διδακτικών Βιβλίων (Ο.Ε.Δ.Β.)]
Περισσότερα -

Βιολογία Γ΄ λυκείου
Θετικής κατεύθυνσης
Νότα Λαζαράκη
[Πουκαμισάς]
Περισσότερα -

Βιολογία Γ΄ λυκείου
Θετικής κατεύθυνσης
Πηνελόπη Λ. Σωτηρίου, Δημοσθένης Καρυοφύλλης
[Σαββάλας]
Περισσότερα -

Βιολογία Γ΄ λυκείου
Γενικής παιδείας
Λάζαρος Γ. Μαλής
[Ζήτη]
Περισσότερα -

400 ασκήσεις βιολογίας Γ΄ λυκείου
Θετικής κατεύθυνσης
Κώστας Ρ. Παπαζήσης
[Εν Δυνάμει]
Περισσότερα -

Βιολογία Γ΄ λυκείου γενικής παιδείας
Βασίλης Καμινέλλης
[Ελληνοεκδοτική]
Περισσότερα -

Βιολογία κατεύθυνσης
Θέματα εξετάσεων 2000-2009: Ιουνίου, επαναληπτικές Ιουνίου, εσπερινών λυκείων, Ελλήνων εξωτερικού
[Εν Δυνάμει]
Περισσότερα -

Βιολογία Γ΄ λυκείου
Γενικής παιδείας
Νότα Λαζαράκη, Ιορδάνης Σαράντος
[Πουκαμισάς]
Περισσότερα -

Βιολογία Γ΄ γυμνασίου
Συλλογικό έργο, Χαρίλαος Μέγας, Ελευθέριος Π. Νεοφύτου, Ελένη Φωτάκη
[Ζήτη]
Περισσότερα -

Θέματα διδακτικής της βιολογίας
Διδασκαλία και μάθηση βιολογικών εννοιών στη δευτεροβάθμια εκπαίδευση
Βασιλική Ζόγκζα
[Μεταίχμιο]
Περισσότερα -

100 θέματα βιολογίας Γ΄λυκείου
Θετικής κατεύθυνσης: Για μια ποιοτική επανάληψη
Β. Παπαδοπούλου, Ν. Χρυσοχοΐδου
[Εκδόσεις Μαυρίδη]
Περισσότερα -

100 θέματα βιολογίας Γ΄λυκείου
Γενικής παιδείας: Για μια ποιοτική επανάληψη
Β. Παπαδοπούλου, Ν. Χρυσοχοΐδου
[Εκδόσεις Μαυρίδη]
Περισσότερα -

Βιολογία Α΄ γυμνασίου
Νίκος Ι. Τζαβάρας
[Σαββάλας]
Περισσότερα -

Βιολογία Γ΄ ενιαίου λυκείου
Γενικής παιδείας
Γεώργιος Πανταζής, Βασιλική Γεωργίου, Νίκος Μακροδήμος
[Εκδοτικός Όμιλος Συγγραφέων Καθηγητών]
Περισσότερα -

Βιολογία Α΄ γυμνασίου
Γ. Βακερλής, Στέφανος Μπούσιος
[Ελληνοεκδοτική]
Περισσότερα -

Βιολογία Α΄ γυμνασίου
Αύρα Ευαγγελάτου, Νίκος Μπαμπίλης
[Εκδόσεις Πατάκη]
Περισσότερα -
Βιολογία θετικής κατεύθυνσης Γ΄ λυκείου
Νικολέττα Μαργαρίτη
[Εκδοτικός Οίκος Α. Α. Λιβάνη]
Περισσότερα -

Βιολογία Γ΄ λυκείου
Θετικής κατεύθυνσης
Νίκος Ι. Τζαβάρας
[Σαββάλας]
Περισσότερα -

Βιολογία Γ΄ γυμνασίου
Πηνελόπη Λ. Σωτηρίου
[Σαββάλας]
Περισσότερα -

Κριτήρια αξιολόγησης Βιολογία Γ΄ λυκείου
Θετικής κατεύθυνσης
Νικολέττα Μαργαρίτη
[Εκδοτικός Οίκος Α. Α. Λιβάνη]
Περισσότερα
